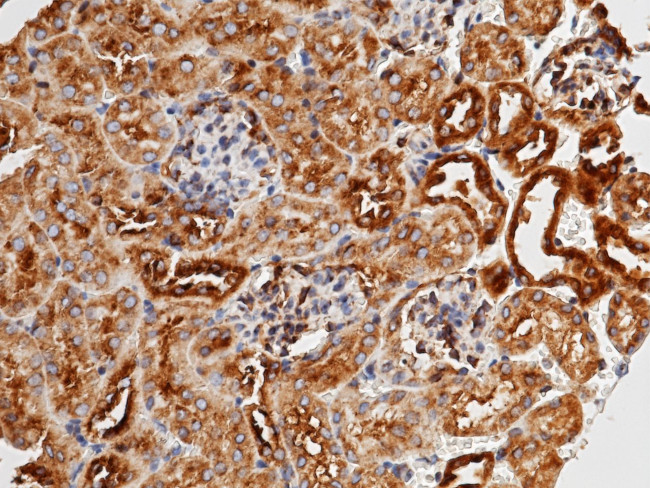
METAP2 Antibody in Immunohistochemistry (Paraffin) (IHC (P))

Search
Invitrogen
METAP2 Polyclonal Antibody
{{$productOrderCtrl.translations['antibody.pdp.commerceCard.promotion.promotions']}}
{{$productOrderCtrl.translations['antibody.pdp.commerceCard.promotion.viewpromo']}}
{{$productOrderCtrl.translations['antibody.pdp.commerceCard.promotion.promocode']}}: {{promo.promoCode}} {{promo.promoTitle}} {{promo.promoDescription}}. {{$productOrderCtrl.translations['antibody.pdp.commerceCard.promotion.learnmore']}}
产品信息
PA5-81445
种属反应
宿主/亚型
分类
类型
抗原
偶联物
形式
浓度
规格
纯化类型
保存液
内含物
保存条件
运输条件
RRID
产品详细信息
This product is preservative free. It is recommended to add sodium azide to avoid contamination (final concentration 0.05%-0.1%).
This antibody has specificity for Mouse METAP2/MAP2.
靶标信息
The ADP-ribosylation factor (Arf) family are highly conserved members of the Ras superfamily of regulatory GTP-binding proteins. Arf proteins participate in routing of intracellular proteins to and within the Golgi complex. Cellular functions include maintenance of organelle integrity, coat protein assembly, as an activator of phospholipase D. The Arf family is divided functionally into the Arf and the Arf-like (Arl) proteins. The ARF proteins are categorized as class I (ARF1, ARF2 and ARF3), class II (ARF4 and ARF5) and class III (ARF6) and members of each class share a common gene organization.
仅用于科研。不用于诊断过程。未经明确授权不得转售。
篇参考文献 (0)
生物信息学
蛋白别名: eIF-2-associated p67; Initiation factor 2-associated 67 kDa glycoprotein; initiation factor 2-associated protein (p67); MAP 2; metAP 2; Methionine aminopeptidase 2; p67; p67eIF2; Peptidase M; peptidase M 2
基因别名: 4930584B20Rik; A930035J23Rik; AI047573; AL024412; Amp2; AU014659; Metap2; Mnpep; p67; P67eif2
UniProt ID: (Mouse) O08663
Entrez Gene ID: (Mouse) 56307